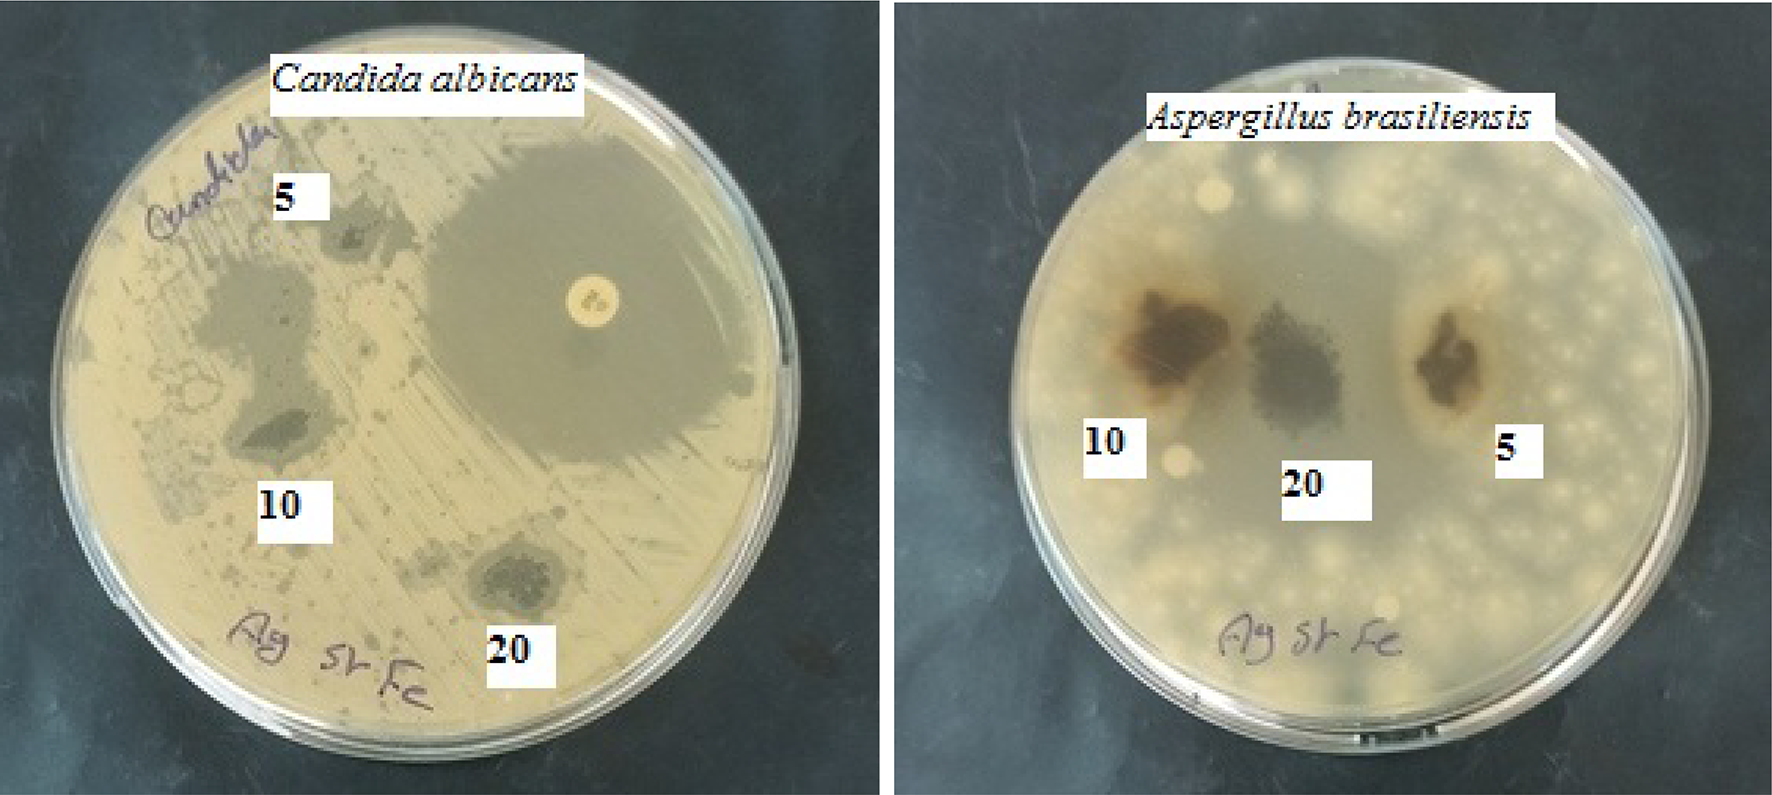
Fig. 15

Fig. 15

The antifungal activity of Ag/Sr0.85Ag0.15FeO3−δ composite (Candida albicans (ATCC 10231)) and Aspergillus brasiliensis (ATCC 16404)) at concentrations of 5, 10, and 20 mg.
The antifungal activity of Ag/Sr0.85Ag0.15FeO3−δ composite (Candida albicans (ATCC 10231)) and Aspergillus brasiliensis (ATCC 16404)) at concentrations of 5, 10, and 20 mg.